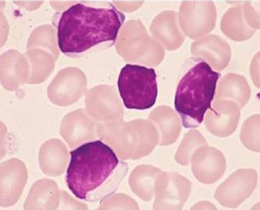

第6回 「マンスリー形態マガジン」 2011年9月号
前 略
真夏を彩る東北四大祭りは閉幕を迎え、祭りのあとの少し寂しい気持ちです。今年は震災の影響で人手が少なかったと聞いていますが、被災地の皆様にとっては複雑なお気持ちかも知れません。
私は15年前の1996年、青森の知人のお世話で、「青森のねぶた」にハネトとして参加し、大変感激したことが思い出されます。狂おしいほどに浸みいる鐘や笛の音、奥深く振舞う太鼓の響きの中で”ラッセラー、ラッセ!”の掛け声のもと津軽の魂と生命を揺さぶる饗宴に酔いしれました。
48歳の頃の私にとって、初めての祭りの主人公として振舞った大切な想い出であり、今でも心に深く刻まれております。
情熱の祭りが終演を告げるとき、東北地方は初秋の訪れを迎えるといわれますが、被災地の皆様の一日も早い復興と創生をお祈り申し上げる次第です。
今回もリンパ球を中心に試みましたが、そろそろリンパ球系の鑑別も間近いかも知れません。
形態学スキスキグループのみなさまのご参加をお待ちしております!
草々
形態マガジン号キャプテン 阿南 建一 
問題
提示の6例は白血球増加を呈し、末梢血にリンパ球様細胞が増加していました。臨床へ如何に報告しますか。選択項目から所見および疾患名を選んで下さい。
このようなリンパ球が3,600/μlみられました。
-
PB-MG.1000

このようなリンパ球が68%みられました。
-
PB-MG.1000

このようなリンパ球が42%みられました。
-
PB-MG.1000

このようなリンパ球が40%みられました。
-
PB-MG.1000

このようなリンパ球が82%(39,360/μl)みられました。
-
PB-MG.1000

このようなリンパ球が88%(18,832/μl)みられました。
-
PB-MG.1000

解答・解説
-
 (成人例 PB-MG1000)
(成人例 PB-MG1000)

- このようなリンパ球が3,600/μlみられました。
【選択所見】
1. 成熟リンパ球がみられる
2.顆粒リンパ球がみられる
【考えられる疾患】
5. 慢性NK細胞増加症
【ねらい】
成熟リンパ球の増加のもと顆粒を有するリンパ球(顆粒リンパ球;*LGL)が3,600/μlみられました。WHO分類の基準から顆粒リンパ球が2,000/μlを超えるものについてはT-細胞大顆粒リンパ性白血病や慢性NK細胞増加症を考えます。
ただし、両者の鑑別は困難ですが、前者はCD3,CD8が陽性でT細胞受容体(TCR)α,β陽性とされ、後者はCD3陰性でCD16,CD56陽性とされます。
本例は慢性の経過でCD16,56陽性により後者に診断されました。
* (large granular lymphocyte)
-
 (成人例 PB-MG1000)
(成人例 PB-MG1000)

- このようなリンパ球が68% みられました。
【選択所見】
4. 明瞭な核小体を有するリンパ球がみられる
【考えられる疾患】
4. 前リンパ球性白血病
【ねらい】
N/Cが高く、明瞭な核小体を有するリンパ球が68%みられたことより異常リンパ球としてのポイントが高くなります。WHO分類では末梢血の前リンパ球が55%以上を超え、CD19, CD20, CD22, FMC7*, sIgM±sIgDが陽性によりB細胞性の前リンパ球性白血病に分類されます。本例は特徴的な臨床所見の孤立性脾腫(リンパ節腫脹を伴わない脾腫)が著明と上記マ ーカーが陽性よりB細胞性前リンパ球性白血病と診断されました。 *(B細胞活性化抗原)
-
 (成人例 PB-MG1000)
(成人例 PB-MG1000)

- このようなリンパ球が42% みられました。
【選択所見】
3. 顕著な核形不整を有するリンパ球がみられる
5. アーテイファクト的な変性リンパ球がみられる
【考えられる疾患】
7. アーテイファクト(多発性骨髄腫の経過中)
【ねらい】
核形不整で一部顆粒を有するリンパ球が42%みられました。CASE4.のATLLに比べ、濃染性が強いことでATL細胞を疑いますが、核形は盛り上がりがなく平坦状であり、アズール顆粒を有する点が異なる所見と思われます。また、抗HTLV-Ⅰ抗体が陰性でした。本例は多発性骨髄腫の治療(メルファラン)経過中に出現したもので翌日には消失していました。
-
 (小児例 PB-MG1000 )
(小児例 PB-MG1000 )

- このようなリンパ球が40% みられました。
【選択所見】
3. 顕著な核形不整を有するリンパ球がみられる
【考えられる疾患】
6. 成人T細胞白血病・リンパ腫(ATLL)
【ねらい】
核形不整はCASE3.に比べ盛り上がり状を呈し花弁状と形容される細胞が40%みられました。形態的にはATL細胞を疑うことになりますが、表面マーカーでもCD2,CD3,CD4,CD5,CD25などが陽性,抗HTLV-Ⅰ抗体も証明されたことよりATLLと診断されました。
-
 (小児例 PB-MG1000)
(小児例 PB-MG1000)

- このようなリンパ球が40% みられました。
【選択所見】
1. 成熟 リンパ球がみられる
【考えられる疾患】
2. 百日咳感染症
【ねらい】
成熟リンパ球が82%(39,360/μl)みられました。末梢血にリンパ球が5,000/μl以上を超えることは腫瘍性が疑われます。このような場合はリンパ球の質的所見から確認するようにします。全般に小~中型リンパ球でN/Cは低く、核網(クロマチン)は粗鋼のようです ので腫瘍性のポイントは低くなります。
本例は百日咳菌(Bordetella pertussis)が検出され、小児年齢も考慮して百日咳感染症と診断されました。
-
 (小児例 B-MG1000)
(小児例 B-MG1000)
- このようなリンパ球が88%(18,832/μl)みられました。
【選択所見】
1. 成熟 リンパ球がみられる
【考えられる疾患】
4. 慢性リンパ性白血病
【ねらい】
成熟リンパ球が88%(18,832/μl)みられ量的条件から腫瘍性を考えますが、本例も質的所見から確認します。全般に小型ながらN/Cが高く、一部に核網の繊細なものがみられることにより腫瘍性を考え、高齢を加味しますと慢性リンパ性白血病(CLL)を疑います。診断には表面マーカーになりますので、CD5・CD19・CD20(dim*),sIgM(dim)が陽性であったことよりB細胞性のクローナルな異常を考え、慢性リンパ性白血病(CLL)と診断されました。
* (発現量が低い)
これから先のページでは、医療関係者の方々を対象に医療機器・体外診断薬等の製品に関する情報を提供しております。当社製品を適正に使用していただくことを目的としており、一部の情報では専門的な用語を使用しております。
一般の方への情報提供を目的としたものではありませんので、ご了承ください。
医療関係者の方は、次のページへお進みください。
(お手数ですが、「進む」ボタンのクリックをお願いします)
